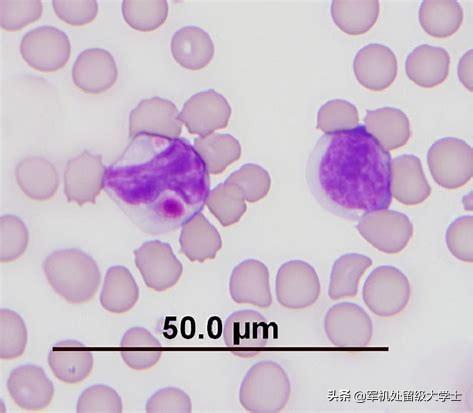

Comment les dauphins combattent-ils leurs propres cellules cancéreuses ?
Comment les dauphins combattent-ils leurs propres cellules cancéreuses ?
Nous savons que le cancer survient à la suite d'une mutation des cellules.
Selon la loi de 1977L'épidémiologiste Richard Peto a mis en avant le "paradoxe de Peto" : plus le nombre de cellules est élevé, plus la base est grande, plus les risques de lésions naturelles sont élevés, de sorte que les grands animaux sont plus susceptibles d'être atteints d'un cancer que les petits.
Dans une certaine mesure, il n'y a rien de mal à cette logique : les éléphants ont 100 fois plus de cellules que les cellules humaines, ce qui signifie que les éléphants sont 100 fois plus susceptibles de développer un cancer que les humains ?
Par ailleurs, les statistiques montrent que le nombre de décès par cancer dans les populations d'éléphants est de 5 %, ce qui est bien inférieur aux 20 à 25 % observés chez l'homme.
Les éléphants, mais aussi les animaux qui vivent plus longtemps, comme les poissons-globe, les dugongs, les rats-taupes nus et les baleines boréales, sont en grande partie protégés du cancer.
Cela fait des envieux ! Les scientifiques ont également étudié le mécanisme qui produit ce phénomène.
Dans le cas des éléphants, par exemple, les scientifiques ont découvert qu'ils possèdent 20 copies d'un gène appelé P53 dans leur génome, alors que les humains et les autres mammifères n'ont qu'une seule copie de ce gène dans leur corps.
Cette photo est très révélatrice de la taille des cochons d'Inde.
Ce gène est également connu sous le nom de "gène suppresseur de tumeur". Sa fonction est la suivante : lorsque l'ADN cellulaire est endommagé et muté, ce gène répare le gène malade, réduisant ainsi le risque de cancer. Les 20 gènes suppresseurs de tumeurs chez les éléphants équivalent à 20 polices d'assurance, contre 1 chez les humains !
En plus des gènes, dans le cas du capybara, il possède également sa propre arme magique anti-cancer, à savoir l'acide hyaluronique, ce qui semble être un aspect très spécialisé. En fait, il existe un nom d'acide hyaluronique dont vous avez certainement déjà entendu parler, à savoir l'acide hyaluronique, qui a un large éventail d'applications dans les produits de soins de la peau.
Que fait-il ?
Ce produit est excellent pour absorber et retenir l'eau. La première utilité de son existence est la lubrification, et pas tellement en tant qu'agent anticancéreux, mais plutôt pour permettre aux dauphins de l'aquarium d'étirer leur peau plus librement.
Bien qu'il n'ait pas d'effet anticancéreux, des recherches ont montré que son existence est l'une des principales raisons pour lesquelles les poissons-globes sont capables de s'immuniser contre le cancer ; sans lui, les cellules des poissons-globes deviennent très rapidement cancéreuses, et la lutte contre le cancer semble être aussi simple que de "faire le travail à la main".
Enfin, je plaisante, une raison très importante pour laquelle les oryctéropes sont immunisés contre le cancer est qu'ils ont un bon état d'esprit :

Parce qu'il n'y a pas d'ennemi naturel, il est temps de manger et de boire, de ne pas être pressé, tout est détendu, c'est la vie de dauphin du dauphin dépeint !


Grâce à l'étude des dauphins d'eau et des éléphants, qui sont des animaux immunisés contre le cancer, les êtres humains disposent de connaissances plus récentes en matière de prévention et de traitement du cancer, mais il reste bien sûr un long chemin à parcourir avant l'application clinique.
La science peut être amusante, alors n'hésitez pas à suivre cette fille !
Le dauphin est le plus grand rongeur du monde et, à mesure que les animaux grossissent, ils doivent trouver des moyens de lutter contre le cancer.
Cela vaut non seulement pour le dauphin, mais aussi pour les grands animaux tels que les éléphants et les baleines, qui doivent avoir leurs propres secrets en matière de prévention du cancer. L'étude des méthodes de prévention du cancer de ces grands animaux pourrait aider les scientifiques à trouver de nouveaux moyens de traiter les cancers chez l'homme. La comparaison de son génome avec ceux d'autres rongeurs nous aidera à comprendre comment la nature a amélioré les capacités de lutte contre le cancer du dauphin au cours de son évolution.
Normalement, les rongeurs tels que les souris domestiques et les campagnols des prairies sont de petite taille, ce qui leur permet d'éviter les prédateurs, et grâce à leur petite taille, les rongeurs ont extrêmement bien réussi à survivre et à se reproduire dans le monde naturel. Cependant, lorsque les ancêtres du dauphin sont entrés en Amérique du Sud il y a environ 40 millions d'années, l'absence de prédateurs naturels pour les rongeurs en Amérique du Sud a fait perdre l'avantage de la petite taille et a mis en évidence les inconvénients ; les avantages et les inconvénients ont été inversés et la sélection naturelle a commencé à pousser les ancêtres du dauphin à augmenter leur taille.

ILLUSTRATION : L'Amérique du Sud est un véritable paradis pour les dauphins d'eau. En l'absence de prédateurs naturels, le dauphin est très bouddhiste.
Difficultés pour les personnes de petite taille
Pour les animaux à sang chaud, plus la taille de leur corps est petite, plus ils ont besoin de manger chaque jour et plus ils doivent chercher quelque chose à manger, sinon ils peuvent facilement mourir de faim. En effet, en tant que mammifères à sang chaud, plus la taille du corps est petite, plus le rapport entre la surface corporelle et le poids du corps est élevé, et une augmentation de ce rapport entraîne une dissipation plus rapide de la chaleur, pour la même raison que le fait de verser le même poids et la même température d'eau chaude dans un grand plat dissipera la chaleur plus rapidement que si l'eau était restée dans une casserole. Les animaux tirent toute leur chaleur de la combustion des aliments. Ainsi, en Amérique du Sud, où il n'y avait pas de prédateurs naturels, l'ancêtre du dauphin d'eau a commencé à évoluer vers une taille gigantesque, devenant le plus grand rongeur de la planète.

Difficultés à passer d'une petite taille à une grande taille
Lorsque les animaux passent d'une petite taille à une grande taille, ils rencontrent rapidement un obstacle fatal sous la forme d'une augmentation rapide du risque de cancer cellulaire, et en effet, dans les populations qui ont un cancer cellulaire, le risque de cancer est plus élevé que dans les autres.Les statisticiens de la santé ont observé qu'en moyenne, les personnes de grande taille sont légèrement plus susceptibles de développer un cancer que les personnes de petite taille, le risque de cancer augmentant d'environ 1,1 fois pour chaque augmentation de 10 cm de la taille.. Parmi les chiens domestiques, les grands chiens pesant plus de 35 kg ont un risque de cancer 150 fois plus élevé que les petits chiens !

ILLUSTRATION : Les grands chiens ont un risque de cancer beaucoup plus élevé que les petits chiens, tout simplement parce que les grands chiens ont plus de cellules. Plus il y a de cellules, plus la probabilité que des cellules cancéreuses apparaissent naturellement est élevée, à condition que le risque de cancer reste le même.
Si ce rapport était constant dans la nature, alors avec une croissance en taille de plusieurs dizaines voire centaines de fois, l'animal aurait pu développer toutes sortes de cellules cancéreuses sur l'ensemble de son corps avant de naître, et il serait mort avant de naître. Mais les grands animaux qui abondent dans la nature, comme les éléphants, les hippopotames, les rhinocéros, les baleines, etc., suggèrent qu'un tel raisonnement est problématique, et c'est le paradoxe le plus célèbre dans le domaine de la recherche sur le cancer, leParadoxe de Peto(Paradoxe de Peto).

Illustration : la ligne rouge représente le taux de cancer prévu et la ligne bleue le taux de cancer réellement observé. Des expériences ont montré que le risque de cancer chez différentes espèces animales est indépendant de la taille de ces espèces. Ce n'est qu'au sein d'une même espèce animale que la taille a une relation proportionnelle positive claire avec le cancer, ce qui est connu sous le nom de paradoxe de Peto.
C'est le paradoxe de Peto qui a suscité l'intérêt des zoologistes pour l'étude de la taille des animaux et du cancer chez les animaux. Le dauphin n'est pas le premier animal à faire l'objet d'une étude ; des recherches ont déjà été menées sur les raisons pour lesquelles les éléphants survivent et ne naissent pas avec des tumeurs sur tout le corps. L'une de ces raisons est que les éléphants ont amplifié le nombre d'un oncogène important - TP53 - au cours de leur évolution ; les humains n'ont qu'une paire de gènes TP53, une de chaque parent. Les humains n'ont qu'une paire de gènes TP53, une par parent, alors que les éléphants en ont vingt paires. Ce gène a permis de réduire considérablement le taux de cancer chez les éléphants, qui est passé de 35 à 50 % chez l'homme à moins de 5 %. Certains malchanceux naissent avec une mutation dans l'un des gènes P53, et le taux de cancer pour ce groupe atteint alors 90 %.

ILLUSTRATION : Les chiens n'ont qu'une seule paire de gènes TP53, tout comme les humains, mais les chiens sont plus petits que les humains et ont donc un taux de cancer inférieur à celui des humains.
La fonction du gène TP53 est de produire une protéine qui vérifie si le matériel génétique (ADN) de la cellule est normal. S'il constate que le matériel génétique de la cellule est gravement endommagé, il interdit à la cellule de se diviser, l'incite à réparer l'ADN endommagé et, si la situation est si grave qu'elle ne peut être réparée, P53 ordonne à la cellule de se suicider. En bref, le gène P53 est le surveillant qui empêche la cellule de se transformer en cellule cancéreuse, et plus il y a de surveillants, moins il y a de chances qu'ils soient trompés.

Quel est le secret de la prévention du cancer chez le poisson-globe ?
Les dauphins adultes pèsent jusqu'à 55 kg et ont une durée de vie de 6 à 7 ans à l'état sauvage, et jusqu'à 15 ans à l'état domestique. La plupart des autres rongeurs, en revanche, pèsent en grammes, généralement de 20 à 200 grammes seulement, et ont une durée de vie courte, de 1 à 3 ans seulement. Par conséquent, lorsque les ancêtres du dauphin ont commencé à évoluer vers une taille gigantesque, ils ont dû trouver un moyen de prévenir le cancer.
En 2018, l'équipe de chercheurs d'Herrera-Álvarez a découvert que le système immunitaire du dauphin d'eau est mieux à même de détecter et de détruire les cellules qui se divisent trop rapidement, une expression qui a le pouvoir de tuer. En d'autres termes, les dauphins d'eau ont développé leur propre immunothérapie contre le cancer. C'est probablement le secret de la prévention du cancer chez le dauphin. Espérons que les scientifiques trouveront bientôt des moyens de l'appliquer à des projets de santé humaine, comme le réglage du système immunitaire humain.
Suivez-moi si vous le souhaitez.
Merci pour les félicitations.
La façon dont l'homme peut s'attaquer au cancer est peut-être cachée dans le code génétique des grands mammifères, attendant d'être découverte par l'homme.
Le nom "cancer" effraie les gens, et les travailleurs médicaux rêvent d'abattre la montagne difficile qu'est le "cancer". Le corps humain est composé de cellules, les cellules doivent constamment se diviser afin d'actualiser les vieilles cellules flétries, pour maintenir la vitalité du corps, il y a des avantages et des inconvénients à tout, la division cellulaire, l'ADN doit être répliqué, mais le processus de réplication est sujet à l'erreur, en particulier sous l'influence de facteurs chimiques, la probabilité d'erreur augmentera, une nouvelle cellule, son ADN est erroné, le mécanisme de réparation interne du corps humain, si la reconnaissance de l'erreur, c'est bon, si la reconnaissance n'est pas, c'est le "survivant" de la montagne à ronger. Si le mécanisme de réparation interne du corps humain reconnaît l'erreur, alors tout va bien, mais s'il ne la reconnaît pas, alors c'est une cellule cancéreuse qui a "survécu". La prolifération des cellules cancéreuses n'est pas régulée, et c'est une cellule qui est complètement hors de contrôle, et si le corps n'est pas capable de nettoyer ces cellules cancéreuses à temps, alors elles deviendront un cancer à long terme.

Si l'on part du principe que chaque cellule a à peu près la même chance de devenir cancéreuse, on peut en déduire que plus la créature est grande, plus elle a de chances de développer un cancer, car une plus grande taille signifie qu'il y a plus de cellules, et plus de cellules ont plus de chances de commettre des erreurs. Si tel est le cas, les baleines bleues et autres grandes baleines, ainsi que les éléphants sur terre, en tant que grands animaux sur la planète, devraient avoir plus de risques de développer un cancer que les petites créatures telles que les humains, mais ce n'est pas le cas, ce qui est également connu sous le nom de "paradoxe de Peto", proposé par l'épidémiologiste britannique Richard Peto (Richard Peto). C'est le fameux "paradoxe de Peto", proposé par l'épidémiologiste britannique Richard Peto (Richard Peto). Comment expliquer ce paradoxe ? Peto a émis une hypothèse :Dans la nature, les animaux doivent disposer d'un mécanisme unique de suppression du cancer.

Le dauphin d'eau mentionné dans le titre n'est qu'un des animaux dotés de ce mécanisme de suppression du cancer. Le dauphin d'eau est une sorte d'herbivore semi-aquatique, c'est aussi le plus grand rongeur du monde, pesant 27-50㎏, longueur du corps 100-130cm, hauteur des épaules un demi-mètre, c'est vraiment un gros rat "devenu fin", il vit dans les zones marécageuses luxuriantes d'Amérique du Sud, ils restent souvent au bord de l'eau, et mangent quand ils ont faim. "Il vit dans les zones marécageuses d'Amérique du Sud où les plantes sont florissantes. Il reste souvent au bord de l'eau, mange des plantes aquatiques lorsqu'il a faim, et sort parfois pour manger du riz, des légumes et des fruits, de la canne à sucre, et se mêle également au bétail pour manger des pâturages, et le vent soufflant l'herbe à voir n'est pas nécessairement du bétail et des moutons, mais aussi des dauphins d'eau. Il peut se cacher dans l'eau à tout moment pour éviter l'attaque des prédateurs.

Les scientifiques ont découvert, grâce à leurs recherches, la raison pour laquelle le poisson-globe n'est pas susceptible de développer un cancer.C'est parce que son système immunitaire peut rapidement détecter les cellules qui se divisent trop rapidement et les détruire.Il est vrai qu'il dispose d'un excellent système immunitaire. Par exemple, chez les éléphants d'Afrique, le taux de cancer n'est que de 5 %, alors qu'il atteint 11 à 25 % chez les êtres humains. Grâce à l'étude du génome des éléphants d'Afrique, les scientifiques ont découvert l'existence d'oncogènes dans le génome, jusqu'à 20 paires de gènes TP53, alors que chez les êtres humains, il n'y en a qu'une seule paire ; il semble que la nature ne nous favorise pas du tout. Avec autant d'oncogènes, il est difficile pour les éléphants de contracter un cancer.

Le nudibranche (ou rat-taupe nu, comme on l'appelle) est également un animal moins sensible au cancer. Il a la particularité de contenir une grande quantité d'acide hyaluronique, que l'on trouve dans son corps.Cette substance empêche les cellules cancéreuses de s'agglutiner, et celles qui ne le font pas sont détruites une à une.Peut-on l'attribuer à la teneur élevée en acide hyaluronique des rats-taupes ? Personnellement, je pense que des recherches plus approfondies sont nécessaires avant de tirer des conclusions, car les rats-taupes nus sont également résistants à la toxicité, et ces secrets sont cachés dans leur code génétique.

Les baleines n'ont pratiquement jamais de cancer, même si elles vivent toutes très longtemps.
La solution pour "vaincre le cancer", l'objectif ultime de la médecine moderne, pourrait bien être cachée dans le code génétique de ces animaux.
La raison principale est que l'esprit est bon et qu'il peut manger et jouer ! Les hommes et les animaux ont pour principe que plus on est refoulé, plus on a de chances d'avoir un cancer, et il y a bien sûr des raisons génétiques à cela :

I. Présentation du poisson-globe
Le dauphin est un animal semi-aquatiqueherbivoreIl s'agit également du plus grandrongeur. Longueur du corps 1-1,3 m, hauteur environ 0,5 m, poids 27-50 kg. Habite les zones marécageuses à végétation dense. Le plus souvent en groupes de 20 individus au maximum. Préfère les activités nocturnes, ne creuse pas de terriers. Phytophage. Lent à se déplacer, mais réagit rapidement au danger et peut s'échapper en sautant dans l'eau. Son espérance de vie est de 8 à 10 ans.
Principalement en Amérique du Sud, notamment dans le sud du Brésil et le nord de l'Argentine,Columbia (District de, ou Université, etc.)Sud-est,Venezuelail y aParaguay。
Deuxièmement, la taille du poisson-globe est en fait prédisposée au cancer

cytoplasme
Une nouvelle étude publiée dans la revue scientifique BioRxiv indique que des scientifiques d'Amérique du Sud, de Suède et des États-Unis ont trouvé des indices sur le système d'hyperpropulsion après avoir séquencé l'ADN du dauphin d'eau. Ils y ont également trouvé des mécanismes anticancéreux possibles, qui seront utilisés dans de futures recherches anticancéreuses.
En plus de devoir lutter pour trouver plus de nourriture, les dauphins semblent présenter un risque plus élevé de développer un cancer. Si chaque cellule a une certaine probabilité de devenir cancéreuse, il est probable que les animaux ayant plus de cellules soient plus susceptibles de développer un cancer. Mais le dauphin d'Amérique du Sud est l'un des chanceux qui échappe à cette théorie.

III. comment le poisson-globe combat les cellules cancéreuses
Comment le poisson-globe combat-il les cellules cancéreuses ?
Les scientifiques qui étudient les dauphins ont découvert que le système immunitaire de leurs gènes est plus performant et plus rapide pour détecter et détruire les cellules cancéreuses, de sorte que le dauphin disposerait d'une immunothérapie anticancéreuse unique.
Vincent Lynch, biologiste spécialiste de l'évolution du cancer à l'université de Chicago, a également déclaré : "J'ai été agréablement surpris par la capacité du dauphin à lutter contre le cancer et je n'aurais jamais pensé qu'elle était liée au système immunitaire. Cela pourrait peut-être nous donner une nouvelle inspiration pour ouvrir un champ de bataille contre le cancer."
En général, chez les humains, les porcs et les autres mammifères, les cellules se développent et se divisent jusqu'à ce qu'elles entrent en contact avec d'autres cellules, et ce contact cellulaire peut entraîner l'arrêt de la division ou la mort. Les cellules des dauphins d'eau sont plus sensibles au contact avec d'autres cellules. De plus, après des recherches, les scientifiques ont découvert une autre caractéristique des dauphins d'eau. Des scientifiques de l'université de Rochester ont placé des cellules de poisson-globe dans des solutions nutritives et, après quelques jours, ils ont constaté que les cellules transformaient ces liquides en une bouillie collante. Ces gels pulpeux sont constitués d'une molécule en forme de chaîne appelée acide hyaluronique. Cet acide hyaluronique se trouve en fait chez les humains et les rats, mais après recherche, l'acide hyaluronique chez les dauphins buffles est cinq fois plus élevé que chez les humains. C'est peut-être la raison pour laquelle les dauphins ont des propriétés anticancéreuses.

IV. l'état d'esprit
Regardez la mentalité du dauphin : manger et boire sans réfléchir, vivre en harmonie avec les autres créatures, avoir de bonnes relations interpersonnelles, pouvoir manger et dormir, ne pas être pressé, ne pas être impatient, être curieux, aimer la vie, comment est-il possible d'avoir un cancer ?
Comment les dauphins combattent-ils leurs propres cellules cancéreuses ?
Le cancer est un sujet effrayant, mais certains animaux n'ont pas de cancer du tout et semblent être nés avec la capacité de combattre le cancer, et le poisson-globe est l'un d'entre eux.
Le dauphin est un rongeur, de la famille des cochons d'Inde, du genre Daphnia. En entendant son nom, il est facile de penser qu'il est proche des dauphins et des poissons-globe, mais en fait, il est plus proche de la souris et de l'écureuil.

Le dauphin est un herbivore semi-aquatique et le plus grand rongeur du monde. Un dauphin adulte peut mesurer de 1 à 1,3 mètre de long, jusqu'à 0,5 mètre de haut et peser jusqu'à 50 kilogrammes, ce qui lui vaut le surnom de "rat géant".

Le dauphin reste calme face au crocodile !
En raison de son apparence mignonne et de son tempérament doux, le dauphin est très populaire auprès des gens et ses "photos mignonnes" deviennent souvent virales sur l'internet.

Ce gros rat mignon, mais les scientifiques ont découvert une fonction miraculeuse - un anticancéreux naturel, ce qui peut rendre les scientifiques fous de joie, si la recherche est claire sur la raison de l'anticancéreux du dauphin d'eau, les cancers humains n'ont pas l'espoir de guérir ou même de se débarrasser directement du cancer ?
Cependant, les êtres humains actuels ne sont pas encore en mesure de résoudre complètement le problème du cancer, et l'on peut savoir, par projection inverse, que les êtres humains sont encore en train de rechercher le mécanisme anticancéreux du dauphin d'eau, et qu'ils n'ont pas encore complètement compris le mécanisme spécifique, mais que les scientifiques auraient fait quelques progrès.
1) Mécanismes sensibles d'inhibition du contact cellulaire
En général, les cellules du corps d'un animal se développent et se divisent jusqu'à ce qu'elles touchent d'autres cellules et que la division s'arrête ; c'est ce qu'on appelle l'inhibition de contact.
Les scientifiques ont découvert que l'inhibition par contact des cellules de poisson-globe est plus sensible et que les cellules de poisson-globe cessent de croître à une densité cellulaire équivalente à 1/3 de celle d'une souris ordinaire.
Quel est donc le rapport entre ce mécanisme et le cancer ?
Comme nous le savons tous, les cellules cancéreuses sont certaines cellules de l'organisme qui ont développé des mutations génétiques, ce qui fait que ces cellules peuvent proliférer indéfiniment et qu'elles ne cessent de se diviser même lorsqu'elles entrent en contact avec d'autres cellules. En outre, elles ne cessent de se diviser quelle que soit la densité des cellules, de sorte que les cellules cancéreuses forment des tumeurs et que les cellules cancéreuses qui ne peuvent être contenues dans la tumeur se propagent dans toutes les directions.

Le mécanisme d'inhibition de contact de la sensibilité du buffle pourrait-il donc être la clé de la lutte contre le cancer ?
Je ne le pense pas, car le mécanisme est également déterminé génétiquement, et lorsque les gènes sont mutés, ces mécanismes deviennent inefficaces, et l'inhibition de contact très sensible qui se produit normalement n'est plus en vigueur, à moins que ce mécanisme d'inhibition de contact puisse être débarrassé des cellules mutées, ou que les cellules mutées puissent mourir d'elles-mêmes en réponse à une exposition d'intensité plus élevée - mais le rapport Il n'y a aucune mention de cela dans le rapport, donc il ne devrait pas y avoir de telle fonction.
2. l'acide hyaluronique plus long
Les scientifiques ont également découvert un autre "secret", à savoir un acide hyaluronique plus long. Cet acide hyaluronique est également présent chez l'homme et le rat, mais la concentration d'acide hyaluronique est plus élevée que chez l'homme et le rat, et la longueur de l'acide hyaluronique est cinq fois plus importante que chez l'homme.
Les scientifiques ont désactivé le gène qui fabrique l'acide hyaluronique chez le capybara, puis ont introduit le facteur cancérigène dans le capybara. En conséquence, les cellules qui avaient perdu l'effet de l'acide hyaluronique ont commencé à croître rapidement et sauvagement, et le capybara n'était pas différent des rats, qui n'avaient aucune résistance aux cellules cancérigènes.
Cependant, les scientifiques pensent que cet acide hyaluronique, qui ne combat pas le cancer, agit en permettant à la peau des oryctéropes de se contracter librement afin de faciliter leur enfouissement dans d'étroits passages rocheux :
"La capacité à lutter contre le cancer est peut-être le fruit d'un heureux hasard. Lorsque l'acide hyaluronique ultra-long de l'oryctérope transmet des signaux à la cellule, il doit passer par le récepteur CD44, et ces signaux sont censés donner des instructions à la cellule et modifier ainsi sa croissance et sa division. Chez l'oryctérope, le processus de signalisation pourrait avoir véhiculé un message anticancéreux.

Qu'est-ce que cela signifie ? Cela signifie que lorsqu'un gène transmet un message, il transmet également le message de lutte contre le cancer.
Il est donc compréhensible que les scientifiques n'aient pas encore trouvé la nature exacte du message anticancéreux, mais ils supposent que ce message pourrait être inclus dans l'information génétique liée à l'acide hyaluronique ultra-long.
Je tiens cependant à préciser qu'il s'agit là de spéculations, certainement fondées, et non de spéculations sauvages, bien qu'elles ne représentent pas les résultats finaux.
Aucun scientifique n'a été en mesure d'apporter une réponse définitive à la question de savoir comment le dauphin élimine ses propres cellules cancéreuses, et les réponses qui ont pu être données jusqu'à présent sont spéculatives.
Les scientifiques ont échoué dans leur lutte contre le cancer, de nombreuses substances anticancéreuses sont tombées sur le chemin de la recherche, le dauphin d'eau peut être une direction possible, apportant de nouvelles idées inspirantes, mais personne ne sait où se trouve le chemin final.
Bravo aux scientifiques qui travaillent dans l'ombre ! Puissent-ils réussir bientôt à résoudre l'un des grands problèmes de l'humanité !

En général, chez l'homme, la souris ou d'autres mammifères, les cellules se développent et se divisent jusqu'à ce qu'elles entrent en contact avec d'autres cellules, ce qui les fait cesser de se diviser ou mourir complètement, un mécanisme connu sous le nom d'inhibition de contact. Toutefois, les cellules de macrophage sont plus sensibles au contact avec d'autres cellules. Par rapport aux cellules de souris normales, les cellules cessent de croître à environ 1/3 de la densité des cellules de souris normales.
De plus, les scientifiques ont découvert un autre "secret" concernant les cellules du poisson-globe. Des biologistes de l'université de Rochester ont placé des cellules du corps du dauphin dans une solution nutritive et, quelques jours plus tard, ils ont constaté que les cellules transformaient le liquide en une pâte collante. Ces gels pulpeux sont constitués d'une molécule en forme de chaîne appelée acide hyaluronique. Cet acide hyaluronique est également présent chez les humains et les rats, mais la concentration d'acide hyaluronique chez les dauphins d'eau était plus élevée que chez les humains et les rats, et leur acide hyaluronique était cinq fois plus long que celui des humains.
Ces acides hyaluroniques plus longs sont-ils ou non la clé des propriétés anticancéreuses du capybara ? Les scientifiques ont mené d'autres expériences.
Ils ont ajouté des enzymes plasminolytiques au capybara et ont constaté que les cellules ne réduisaient pas leur taux de croissance, mais évoluaient vers des amas de cellules plus épais et plus grands, un phénomène identique à celui des cellules de souris prédisposées au cancer. Ensuite, les scientifiques ont désactivé le gène qui fabrique l'acide hyaluronique chez les guppys, puis ont introduit le facteur cancérigène dans les guppys. Les cellules qui avaient perdu l'effet de l'acide hyaluronique ont alors commencé à se développer rapidement et de manière sauvage. Lorsque les scientifiques ont transféré les cellules à des rats, elles se sont rapidement transformées en tumeurs matures. En un clin d'œil, les dauphins ne se distinguaient plus des rats, qui n'avaient aucune résistance aux cellules cancéreuses.
Cette forme plus longue de l'acide hyaluronique n'a pratiquement aucune propriété anticancéreuse. À l'origine, l'acide hyaluronique permettait à la peau des dauphins d'eau de se contracter librement afin de faciliter leur pénétration dans les passages rocheux étroits. "La capacité à lutter contre le cancer est peut-être le fruit d'un heureux hasard. Lorsque l'acide hyaluronique ultra-long de l'oryctérope transmet des signaux aux cellules, il doit passer par les récepteurs CD44, des signaux qui sont censés donner des instructions aux cellules et ainsi modifier la croissance et la division. Chez l'oryctérope, le processus de signalisation a peut-être transmis en même temps le message anticancéreux". Les biologistes de l'université de Rochester expliquent. L'acide hyaluronique n'est peut-être pas la seule explication à la lutte contre le cancer des oryctéropes, mais la recherche de la vérité ne s'arrêtera jamais.
L'étude des substances anticancéreuses et de leurs fonctions a toujours été un sujet brûlant dans le domaine de la science et de la médecine. Cependant, de nombreuses substances anticancéreuses ont été discréditées au cours du processus de recherche visant à les mettre sur le marché, mais la voie de la lutte contre le cancer est toujours empruntée par de nombreux scientifiques. La découverte d'acide hyaluronique ultra-long dans le corps du dauphin d'eau a apporté une nouvelle inspiration et de nouvelles idées aux scientifiques. On pense que dans un avenir proche, le mécanisme anticancéreux de l'oryctérope sera complètement décrypté par les scientifiques, ce qui apportera un nouvel espoir aux êtres humains dans la lutte contre le cancer.
'




Sur la Terre, une planète pleine d'animaux, le dauphin d'eau se distingue. Plus grand rongeur survivant au monde, 60 fois plus lourd que les rongeurs les plus courants, il a la taille d'un adulte. Il passe ses journées à brouter sur les rives des fleuves d'Amérique du Sud et peut cohabiter pacifiquement avec de nombreux animaux. Mais jusqu'à présent, ce qui fait du dauphin un animal doux était entouré de mystère.

Certains scientifiques ont séquencé l'ADN du dauphin d'eau et y ont trouvé des signes d'un système de croissance en surrégime. Ils ont également découvert que l'oryctérope possède la signature génétique d'un mécanisme anticancéreux supposé. Le dauphin d'eau est un animal emblématique de l'Amérique du Sud. Ses ancêtres ont évolué en Afrique il y a environ 80 millions d'années et sont arrivés en Amérique du Sud 40 millions d'années plus tard. Ses parents sont des rongeurs de taille normale, ne pesant que quelques kilos ou moins. Les rongeurs ont tendance à être petits parce que les corps plus petits se cachent mieux et que les prédateurs beaucoup plus grands peuvent penser qu'ils ne valent pas la peine d'être dérangés. Toutefois, lorsque les daphnies sont arrivées en Amérique du Sud, la région était presque totalement dépourvue de prédateurs, ce qui a peut-être incité leurs ancêtres à commencer à grossir. En l'absence de prédateurs, la pression exercée sur les rongeurs a été réduite.
Selon une étude, le secret de l'évolution du cochon d'Inde vers une telle taille est depuis longtemps caché dans son ADN. Les cobayes - le sous-groupe de rongeurs qui comprend le poisson-globe - possèdent tous une forme unique d'insuline. En plus de réguler la glycémie, l'insuline permet aux cellules de se diviser. Les scientifiques ont découvert que les dauphins d'eau n'ont pas plus d'insuline. Au contraire, des millions d'années de sélection naturelle ont accru la capacité de l'insuline à ordonner aux cellules de se diviser, stimulant ainsi leur croissance et donnant naissance à ce grand rongeur.
Cependant, une telle croissance a ses inconvénients. En plus d'avoir besoin de plus de nourriture pour soutenir un corps plus grand, un dauphin doit également faire face au risque accru de cancer qui accompagne l'augmentation de la taille. Si chaque cellule a une probabilité fixe de devenir maligne, plus un animal a de cellules, plus il risque de développer un cancer. Or, ce n'est pas le cas. Par exemple, un éléphant ne risque pas de développer un cancer bien qu'il soit des milliers de fois plus grand qu'une souris. C'est ce qu'on appelle le paradoxe de Peto, et les biologistes ont identifié plusieurs mécanismes par lesquels les grands animaux ont évolué pour arrêter le cancer avant qu'il ne se déclare.
Les scientifiques ont découvert, par exemple, que les éléphants d'Asie et d'Afrique possèdent des gènes qui réduisent le nombre de mutations cancérigènes lorsque les cellules se divisent. En revanche, les baleines boréales ont développé de meilleurs mécanismes pour empêcher la division cellulaire. Les scientifiques ont découvert que les dauphins d'eau semblent avoir développé une stratégie entièrement nouvelle. Leur génome montre que le système immunitaire du dauphin buffle est beaucoup plus performant pour détecter et détruire les cellules qui se divisent trop rapidement. En d'autres termes, le dauphin d'eau a développé sa propre immunothérapie contre le cancer.
Parmi les rongeurs, le dauphin d'eau est sans doute le plus populaire et le plus grand rongeur du monde !
Au fur et à mesure que les animaux grossissaient, ils ont dû développer la capacité d'éviter une division cellulaire incorrecte.
Qu'il s'agisse de nous, créatures intelligentes, des baleines ou des éléphants, ils ont tous leurs propres secrets en matière de prévention du cancer !
Le dauphin a bon caractère, est purement végétarien, préfère vivre en groupe, est docile et produit des excréments riches en protéines qui constituent un en-cas pour de nombreux animaux, autant de qualités qui lui ont valu d'être élu bon ami dans le règne animal.

Mais chez les souris capturées dans la nature, les scientifiques ont découvert que le taux de cancer atteignait 46 %, alors que chez le poisson-globe, la probabilité n'est que de 14 à 30 %.
Les scientifiques pensent que les dauphins d'eau ont développé un tout nouvel ensemble de tactiques de lutte contre le cancer, et que leurs gènes jouent un rôle très actif dans la détection et la lutte contre les cellules qui se divisent à un rythme anormal, selon les gènes.
Deuxièmement, des concentrations élevées ont été observées chez le dauphin buffleacide hyaluroniqueCette substance est présente dans de nombreux organismes, mais elle n'est présente qu'en plus grande quantité chez le poisson-globe et constitue une molécule plus grande, cinq fois plus longue que chez l'homme.
acide hyaluroniqueOn le trouve également en grande quantité chez le rat-taupe nu, un autre rongeur très connu pour ses vertus anticancéreuses.
Le mécanisme anti-cancer existe dans le corps lui-même, et à l'origine, le gars a un bon tempérament et un bon esprit ! C'est pourquoi il a moins de cancer !
Ces questions et réponses proviennent des utilisateurs du site, elles ne représentent pas la position du site, s'il y a une infraction, veuillez contacter l'administrateur pour la supprimer.